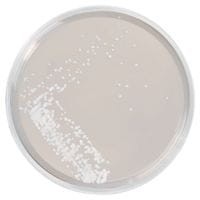
Sabouraud Glucose Agar gotowa pożywka na płytkach do izolacji dermatfitów

Znaleziono produktów: 287
Mueller Hinton Agar gotowa pożywka na płytkach do oznaczania lekowrażliwości

• Opakowanie: 10 szt
• Płytka: 90 mm
• Do oznaczania lekowrażliwości
• Wyrób medyczny: Tak.
X.L.D. Medium gotowa pożywka do identyfikacji Salmonella i Shigella spp

• Opakowanie: 10 szt.
• Płytka: 90 mm.
• Do identyfikacji: Salmonella i Shigella spp.
• Wyrób medyczny: Tak
Brilliant Green Agar (Modified) gotowa pożywka do identyfikacji Salmonelli

• Opakowanie: 10 szt.
• Płytka: 90 mm.
• Do identyfikacji Salmonelli.
• Wyrób medyczny: Tak
Sabouraud Glucose Selective Agar gotowa pożywka na płytkach do izolacji dermatofitów innych grzybów i drożdży

• Opakowanie: 10 szt.
• Płytka: 90 mm.
• Do izolacji dermatyfitów, innych grzybów i drożdży.
• Wyrób medyczny: Tak
Chocolate Agar with Vitox gotowa pożywka na płytkach

• Opakowanie: 10 szt.
• Płytka: 90 mm.
• Wyrób medyczny: Tak
Mannitol Salt Agar gotowa pożywka do oznaczania gronkowców

• Opakowanie: 10 szt.
• Płytka: 90 mm.
• Wyrób medyczny: Tak
CASO Tryptone Soya Agar gotowa pożywka do oznaczania ogólnej liczby drobnoustrojów

• Ilość: 10 szt.
• Płytki: 90 mm
• Wyrób medyczny: Tak
SS Agar gotowa pożywka na płytkach do izolacji Salmonelli i Shigella spp.

• Opakowanie: 10 szt.
• Płytka: 90 mm
• Do izolacji Salmonelli i Shigella spp.
• Wyrób medyczny: Tak
Pseudomonas C-N Selective Agar (Cetrimide Agar) gotowa pożywka do izolacji Pseudomonas aeruginosa

• Opakowanie: 10 szt.
• Płytka: 90 mm.
• Do izolacji Pseudomonas aeruginosa.
Sabouraud Glucose Agar gotowa pożywka na płytkach do izolacji dermatfitów
• Opakowanie: 10 szt.
• Płytka: 90 mm.
• Do izolacji dermatofitów.
• Wyrób medyczny: Tak
Schaedler Anaerobe Agar/blood gotowa pożywka na płytkach

• Opakowanie: 10 szt.
• Płytka: 90 mm.
• Wyrób medyczny: Tak.
MacConkey Agar No. 3 gotowa pożywka na płytkach do wykrywania E. coli

• Opakowanie: 10 szt.
• Płytka: 90 mm.
• Wyrób medyczny: Tak
darmowa i wygodna wysyłka
już od 800 zł netto
Najwyższa jakość
produktów potwierdzona certyfikatami
Zakupy 24h na dobę
wygodne i bezpieczne
bezpłatna konsultacja
z ekspertem online

